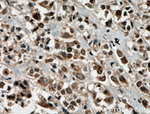
PRMT6 Antibody in Immunohistochemistry (Paraffin) (IHC (P))

Search
Proteintech
PRMT6 Polyclonal Antibody
{{$productOrderCtrl.translations['antibody.pdp.commerceCard.promotion.promotions']}}
{{$productOrderCtrl.translations['antibody.pdp.commerceCard.promotion.viewpromo']}}
{{$productOrderCtrl.translations['antibody.pdp.commerceCard.promotion.promocode']}}: {{promo.promoCode}} {{promo.promoTitle}} {{promo.promoDescription}}. {{$productOrderCtrl.translations['antibody.pdp.commerceCard.promotion.learnmore']}}
产品信息
15395-1-AP
种属反应
已发表种属
宿主/亚型
分类
类型
抗原
偶联物
形式
浓度
规格
纯化类型
保存液
内含物
保存条件
运输条件
产品详细信息
Western blot analysis using this antibody detected a major band around 42 kDa in Hela cells.
Immunogen sequence: MIADRVRTD AYRLGILRNW AALRGKTVLD VGAGTGILSI FCAQAGARRV YAVEASAIWQ QAREVVRFNG LEDRVHVLPG PVETVELPEQ VDAIVSEWMG YGLLHESMLS SVLHARTKWL KEGGLLLPAS AELFIAPISD QMLEWRLGFW SQVKQHYGVD MSCLEGFATR CLMGHSEIVV QGLSGEDVLA RPQRFAQLEL SRAGLEQELE AGVGGRFRCS CYGSAPMHGF AIWFQVTFPG GESEKPLVLS TSPFHPATHW KQALLYLNEP VQVEQDTDVS GEITLLPSRD NPRRLRVLLR YKVGDQEEKT KDFAMED (1-316 aa encoded by BC002729)
靶标信息
Protein arginine N-methyltransferase 6 (PRMT6) PRMT6 demonstrates type I PRMT activity, capable of forming both omega-N monomethylarginine and asymmetric dimethylarginine derivatives on the recombinant glycine- and arginine-rich substrates. cts as a transcriptional coactivator of a number of steroid hormone receptors including ESR1, ESR2, PGR and NR3C1. Promotes fasting-induced transcriptional activation of the gluconeogenic program through methylation of the CRTC2 transcription coactivator. May play a role in innate immunity against HIV-1 in case of infection by methylating and impairing the function of various HIV-1 proteins such as Tat, Rev and Nucleocapsid protein p7.
仅用于科研。不用于诊断过程。未经明确授权不得转售。
生物信息学
蛋白别名: FLJ10559; FLJ51477; Heterogeneous nuclear ribonucleoprotein methyltransferase-like protein 6; Histone-arginine N-methyltransferase PRMT6; HMT1 hnRNP methyltransferase-like 6; PRMT-6; PRMT6; type I; Protein arginine N-methyltransferase 6; unnamed protein product
基因别名: AW124876; BB233495; HRMT1L6; PRMT6
UniProt ID: (Human) Q96LA8, (Mouse) Q6NZB1
Entrez Gene ID: (Human) 55170, (Mouse) 99890